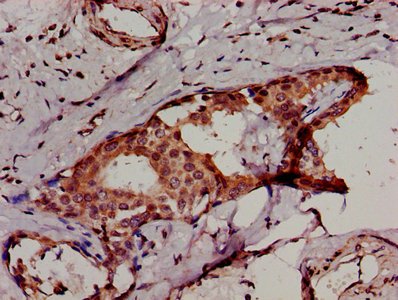

IKBKB Antibody
-
中文名稱:IKBKB兔多克隆抗體
-
貨號:CSB-PA16309A0Rb
-
規格:¥440
-
圖片:
-
Western Blot
Positive WB detected in: A549 whole cell lysate
All lanes: IKBKB antibody at 3.4µg/ml
Secondary
Goat polyclonal to rabbit IgG at 1/50000 dilution
Predicted band size: 87, 86, 30, 80 kDa
Observed band size: 87 kDa -
IHC image of CSB-PA16309A0Rb diluted at 1:500 and staining in paraffin-embedded human breast cancer performed on a Leica BondTM system. After dewaxing and hydration, antigen retrieval was mediated by high pressure in a citrate buffer (pH 6.0). Section was blocked with 10% normal goat serum 30min at RT. Then primary antibody (1% BSA) was incubated at 4°C overnight. The primary is detected by a biotinylated secondary antibody and visualized using an HRP conjugated SP system.
-
Immunofluorescent analysis of A549 cells using CSB-PA16309A0Rb at dilution of 1:100 and Alexa Fluor 488-congugated AffiniPure Goat Anti-Rabbit IgG(H+L)
-
-
其他:
產品詳情
-
產品名稱:Rabbit anti-Homo sapiens (Human) IKBKB Polyclonal antibody
-
Uniprot No.:
-
基因名:
-
別名:I kappa B kinase 2 antibody; I kappa B kinase beta antibody; I-kappa-B kinase 2 antibody; I-kappa-B-kinase beta antibody; IkBKB antibody; IKK beta antibody; IKK-B antibody; IKK-beta antibody; IKK2 antibody; IKKB antibody; IKKB_HUMAN antibody; IMD15 antibody; Inhibitor of kappa light polypeptide gene enhancer in B cells, kinase beta antibody; Inhibitor of nuclear factor kappa-B kinase subunit beta antibody; NFKBIKB antibody; Nuclear factor NF-kappa-B inhibitor kinase beta antibody
-
宿主:Rabbit
-
反應種屬:Human
-
免疫原:Recombinant Human Inhibitor of nuclear factor kappa-B kinase subunit beta protein (395-588AA)
-
免疫原種屬:Homo sapiens (Human)
-
標記方式:Non-conjugated
本頁面中的產品,IKBKB Antibody (CSB-PA16309A0Rb),的標記方式是Non-conjugated。對于IKBKB Antibody,我們還提供其他標記。見下表:
-
克隆類型:Polyclonal
-
抗體亞型:IgG
-
純化方式:>95%, Protein G purified
-
濃度:It differs from different batches. Please contact us to confirm it.
-
保存緩沖液:Preservative: 0.03% Proclin 300
Constituents: 50% Glycerol, 0.01M PBS, pH 7.4 -
產品提供形式:Liquid
-
應用范圍:ELISA, WB, IHC, IF
-
推薦稀釋比:
Application Recommended Dilution WB 1:500-1:5000 IHC 1:500-1:1000 IF 1:50-1:200 -
Protocols:
-
儲存條件:Upon receipt, store at -20°C or -80°C. Avoid repeated freeze.
-
貨期:Basically, we can dispatch the products out in 1-3 working days after receiving your orders. Delivery time maybe differs from different purchasing way or location, please kindly consult your local distributors for specific delivery time.
-
用途:For Research Use Only. Not for use in diagnostic or therapeutic procedures.
相關產品
靶點詳情
-
功能:Serine kinase that plays an essential role in the NF-kappa-B signaling pathway which is activated by multiple stimuli such as inflammatory cytokines, bacterial or viral products, DNA damages or other cellular stresses. Acts as part of the canonical IKK complex in the conventional pathway of NF-kappa-B activation. Phosphorylates inhibitors of NF-kappa-B on 2 critical serine residues. These modifications allow polyubiquitination of the inhibitors and subsequent degradation by the proteasome. In turn, free NF-kappa-B is translocated into the nucleus and activates the transcription of hundreds of genes involved in immune response, growth control, or protection against apoptosis. In addition to the NF-kappa-B inhibitors, phosphorylates several other components of the signaling pathway including NEMO/IKBKG, NF-kappa-B subunits RELA and NFKB1, as well as IKK-related kinases TBK1 and IKBKE. IKK-related kinase phosphorylations may prevent the overproduction of inflammatory mediators since they exert a negative regulation on canonical IKKs. Phosphorylates FOXO3, mediating the TNF-dependent inactivation of this pro-apoptotic transcription factor. Also phosphorylates other substrates including NCOA3, BCL10 and IRS1. Within the nucleus, acts as an adapter protein for NFKBIA degradation in UV-induced NF-kappa-B activation. Phosphorylates RIPK1 at 'Ser-25' which represses its kinase activity and consequently prevents TNF-mediated RIPK1-dependent cell death. Phosphorylates the C-terminus of IRF5, stimulating IRF5 homodimerization and translocation into the nucleus.
-
基因功能參考文獻:
- The results demonstrate that the inhibition of miR-16 renders resistance to paclitaxel in vitro and in vivo by targeting IKBKB via NF-kappa B signaling pathway. PMID: 29935185
- Expression of TAp63, IKKbeta and XBP1s is also increased in livers of obese patients with liver steatosis. PMID: 28480888
- IKK2 and NF-kappaB are related to poor prognosis and are potential predictors of response to platinum-based chemotherapy in high grade serous carcinoma PMID: 29254797
- These studies identify functional EREs in the IKKB promoter and identify IKKB as an ERalpha and NSC35446.HCl-regulated gene, and they suggest that NF-kappaB and IKKB, which were previously linked to antiestrogen resistance, are targets for NSC35446.HCl in reversing antiestrogen resistance. PMID: 28808806
- Curcumin suppressed CXCL5 expression by direct inhibition of IKKbeta phosphorylation, and inhibition of p38 MAPK via induction of negative regulator MKP-1. PMID: 27538525
- This study demonstrated that nerve injury-induced Csf1 upregulation was ameliorated indicating that IKK/NF-kappaBeta-dependent SGC activation induced Csf1 expression in sensory neurons. PMID: 28722693
- Findings uncover a novel function for IKKbeta/mHTTx1 interactions in regulating IL-34 production, and implicate a role for IL-34 in non-cell-autonomous, microglial-dependent neurodegeneration in HD. PMID: 28973132
- HOTAIR operates the action of IKKalpha, IKKbeta, IKKgamma in liver cancer stem cells PMID: 27367027
- These results suggested that APN ameliorated endothelial inflammation and IR through ROS/IKKbeta pathway. PMID: 27639126
- p300-dependent histone H3 acetylation and C/EBPbeta-regulated IKKbeta expression contribute to thrombin-induced IL-8/CXCL8 expression in human lung epithelial cells. PMID: 28428115
- EGFR/PI3K/Akt/mTOR/IKK-beta/NF-kappaB signaling promotes head and neck cancer progression. PMID: 26895469
- our results illustrate a new direction in nitrosourea treatment, and reveal that the combination of ROS-inducing IKKbeta inhibitors with nitrosoureas can be potentially exploited for melanoma therapy PMID: 28107677
- Smad7 expression in necrotizing enterocolitis macrophages interrupts TGF-beta signaling and promotes NF-kappaB-mediated inflammatory signaling in these cells through increased expression of IKK-beta PMID: 26859364
- High IKBKB expression is associated with prostate cancer. PMID: 27577074
- Akt2, Erk2, and IKK1/2 phosphorylate Bcl3, converting Bcl3 into a transcriptional coregulator by facilitating its recruitment to DNA. PMID: 28689659
- Rare variants in IKBKB are associated with decreased waist-to-hip ratio in European-Americans. PMID: 26757982
- pVHL mediates K63-linked ubiquitination of IKKbeta, which plays a role in the regulation of IKK/NF-kappaB signalling. PMID: 27693634
- our results demonstrate that miR-200b, a transcriptional target of NF-kappaB, suppresses breast cancer cell growth and migration, and NF-kappaB activation, through downregulation of IKBKB, indicating that miR-200b has potential as a therapeutic target in breast cancer patients. PMID: 26433127
- The present research concluded that aspirin suppressed prostate cancer cell invasion by reducing MMP-9 activity and uPA expression through decreasing of IKK-beta-mediated NF-kappaB activation, indicating that the ability of aspirin to inhibit cell invasion might be useful in the chemoprevention of metastatic prostate cancer. PMID: 28278500
- miR-429 is involved in regulation of the NF-kappaB pathway by targeting IKKbeta and functions as a tumor suppressor in cervical carcinogenesis. PMID: 27883176
- TLR signaling led to lower expression of LRRC14. PMID: 27426725
- results uncover a previously unidentified role of IKKbeta in regulating glycolysis, sensing low-glutamine-induced metabolic stress, and promoting cellular adaptation to nutrient availability. PMID: 27585591
- data clearly demonstrate that KLHL21 negatively regulates TNFalpha-activated NF-kappaB signaling via targeting IKKbeta, providing new insight into the mechanisms underlying NF-kappaB regulation in cells. PMID: 27387502
- Cis- and trans-gnetin H suppress cytokine response in LPS-stimulated THP-1 cells by preventing activation of key signaling molecules, IKK-beta, IkappaB alpha, and p65, involved in the NF-kappaB pathway. PMID: 27196294
- The neuroprotective effects of celastrol and its analogues may be related to IKKbeta inhibition. PMID: 27931154
- Survivin overexpression activates NFkappaB p65, which is important in the acquisition and maintenance of the oncogenic characteristics of esophageal squamous cell carcinoma. PMID: 26718331
- Over-expressed IKK-Beta inhibits cell apoptosis in laryngeal squamous cell carcinoma. PMID: 26914121
- DAT stabilized IkBa by inhibiting the phosphorylation of Ika by the IkB kinase (IKK) complex. DAT induced proteasomal degradation of TRAF6, and DAT suppressed IKKb-phosphorylation through downregulation of TRAF6 PMID: 26647777
- IFIT5 promotes SeV-induced IKK phosphorylation and NF-kappaB activation by regulating the recruitment of IKK to TAK1. PMID: 26334375
- Down-regulation of IKBKB expression and NFkappaB signaling in microglia/macrophages infiltrating glioblastoma correlates with defective expression of immune/inflammatory genes and M2 polarization that may result in the global impairment of anti-tumor immune responses in glioblastoma. PMID: 26427514
- Combining bortezomib with IKK inhibitor is effective in treating ovarian cancer. PMID: 26267322
- MyD88s is positively regulated by IKKbeta and CREB and negatively regulated by ERK1/2 signaling pathways. PMID: 26669856
- IKK-beta suppresses GLI1 ubiquitination. PMID: 26603838
- we demonstrate that one miR-497, is a likely negative regulator of IKKbeta PMID: 26020802
- In cells with functional KEAP1, RTA 405 increased NRF2 levels, but not IKKb or BCL2 levels, and did not increase cell proliferation or survival. PMID: 26301506
- findings indicate that the IKBKB and POLB SNPs confer no genetic predisposition to SLE risk in this Chinese Han population PMID: 26167925
- Demonstrate the essential role of EGFR/Akt/IkappaBbeta/NF-kappaB pathway in the inhibitory effect of PA-MSHA on invasion and metastasis of HCC through suppressing EMT. PMID: 25066210
- identified IKK-beta as a kinase capable of phosphorylating threonine 3 in N-terminal hungtingtin fragments PMID: 26106822
- The activation of NF-kappaB induced translocation of AMAP1 to cytoplasm from cell membrane and nucleus, which resulted in augmented interaction of AMAP1 and IKKbeta PMID: 24865276
- High IKBKB expression is associated with inflammation in heart Valve Diseases. PMID: 25630970
- These studies not only reinforce the significance of maintaining a homeostatic balance of eNOS and IKKbeta within the cell system that regulates NO production, but they also confirm that the IKKbeta-Hsp90 interaction is favored in a high-glucose environment, leading to impairment of the eNOS-Hsp90 interaction, which contributes to endothelial dysfunction and vascular complications in diabetes. PMID: 25652452
- IKKbeta regulates endothelial thrombomodulin in a Klf2-dependent manner PMID: 25039491
- Studies indicate that transcription factor NF-kappaB plays a key role in numerous physiological processes, and its activation is tightly controlled by a kinase complex, IkappaB kinase (IKK). PMID: 25432706
- Suppression of PKK expression by RNA interference inhibits phosphorylation of IKKalpha and IKKbeta as well as activation of NF-kappaB in human cancer cell lines; thus, PKK regulates NF-kappaB activation by modulating activation of IKKalpha and IKKbeta. PMID: 25096806
- IKBKB-rs3747811AT single nucleotide polymorphism was associated with a significantly increased risk of developing wheezing. PMID: 25326706
- IKKbeta is an IRF5 kinase that instigates inflammation PMID: 25326420
- IKKbeta activates two "master" transcription factors of the innate immune system, IRF5 and NF-kappaB PMID: 25326418
- RTK-mediated Tyr phosphorylation of IKKbeta has the potential to directly regulate NFkappaB transcriptional activation. PMID: 24386391
- Expression of IKBKB gene reduced the cisplain sensitivity of A549 cells. PMID: 24854552
- Gain-of function or knockdown of miR-200c in leiomyoma smooth muscle cells (LSMC) regulated IL8 mRNA and protein expression through direct targeting of IKBKB and alteration of NF-kB activity. PMID: 24755559
顯示更多
收起更多
-
相關疾病:Immunodeficiency 15 (IMD15)
-
亞細胞定位:Cytoplasm. Nucleus. Membrane raft.
-
蛋白家族:Protein kinase superfamily, Ser/Thr protein kinase family, I-kappa-B kinase subfamily
-
組織特異性:Highly expressed in heart, placenta, skeletal muscle, kidney, pancreas, spleen, thymus, prostate, testis and peripheral blood.
-
數據庫鏈接:
Most popular with customers
-
-
YWHAB Recombinant Monoclonal Antibody
Applications: ELISA, WB, IHC, IF, FC
Species Reactivity: Human, Mouse, Rat
-
Phospho-YAP1 (S127) Recombinant Monoclonal Antibody
Applications: ELISA, WB, IHC
Species Reactivity: Human
-
-
-
-
-